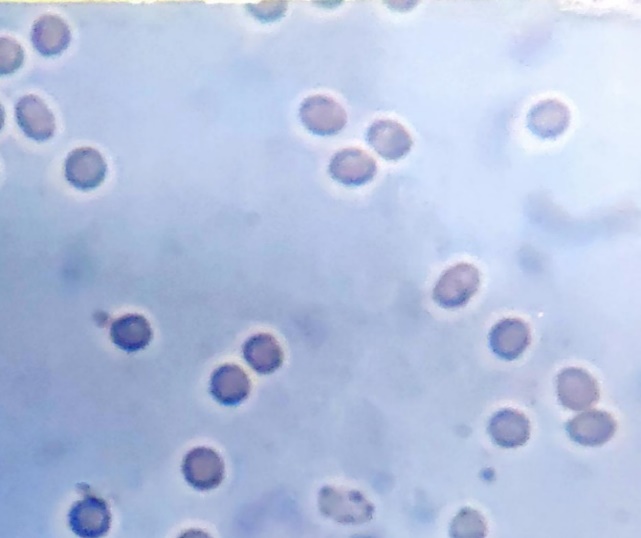

1School of Pharmaceutical Sciences, Lovely Professional University, Phagwara-144411, (Punjab), India. 2School of Bioengineering and Biosciences, Lovely Professional University, Phagwara-144411, (Punjab), India. 3PCTE Group of Institutes, Faculty of Pharmaceutical Science, Baddowal Cant, Ludhiana-142021, (Punjab), India
*Corresponding author: Neha Srivastava; *Email: nehasrvstva@gmail.com
Received: 04 Aug 2023, Revised and Accepted: 25 Sep 2023
ABSTRAC
Objective: Dendrimers are the three-dimensional polymeric architectural motif which bestows an advanced platform for drug delivery and drug targeting. Dendrimers are a novel cargo system that can accommodate larger amounts of the drug in its structure by conjugating the drug with terminal amine functional groups. The present work was designed to develop Fosamprenavir calcium-loaded 5th generation poly (propylene imine) (5G PPI) dendrimers for effective treatment of Human immunodeficiency virus.
Methods: The drug loading was carried out using a direct method with continuous stirring for 48 h. The sample was characterized using different analytical techniques and also evaluated for drug entrapment, drug release, and release kinetics. The hemolytic toxicity studies were also performed and evaluated based on % hemolysis and surface morphology of RBCs after incubating with the prepared formulation.
Results: The Fourier transform infrared (FTIR) and Nuclear Magnetic Resonance (NMR) spectral analysis confirms the conjugation of the Fosamprenavir calcium and dendrimers. Differential scanning calorimetry analysis (DSC) also confirmed the conjugation of the drug with dendrimers. Scanning electron microscopy (SEM) images showcased the spherical floral arrangement of the dendrimer structure. The drug entrapment studies revealed 69.83±0.31% of the drug encapsulated in the dendrimer structure. The drug release studies showed 80.18±0.65% in phosphate buffer pH 7.4 and 68.09±1.78% in acetate buffer pH 5.0. The drug release kinetics showed that the Higuchi release pattern was followed for the release pattern of pH 5 and pH 7.4. The hemolysis study revealed that the conjugation of the drug with 5G PPI dendrimers drastically reduces the hemolysis.
Conclusion: Thus, from the studies, it can be concluded that an efficient drug delivery system can be developed for the anti-retroviral drug Fosamprenavir calcium by loading on 5G PPI dendrimers.
Keywords: HIV, AIDS, Fosamprenavir calcium, Dendrimers, Conjugates, Disease, Toxicity, Hemolysis
© 2023 The Authors. Published by Innovare Academic Sciences Pvt Ltd. This is an open access article under the CC BY license (https://creativecommons.org/licenses/by/4.0/)
DOI: https://dx.doi.org/10.22159/ijap.2023v15i6.49040. Journal homepage: https://innovareacademics.in/journals/index.php/ijap
Dendrimers are hyperbranched structured artificial polymers, getting enormous attention for diverse therapeutic agents [1]. This nanosized complex molecule was first put forward by Fritz Vogtle in 1978, named cascade molecules. After many years of basic discoveries, Tomalia and co-workers formulated an improved category of cascade molecules, termed dendrimers, which is a from the Greek word dendrons means branched-like structure [2]. Newkome and co-workers published the development of a similar kind of structure and termed them arborol derived from the Latin term arbor [3].
Dendrimers are developed in a step-wise pattern starting from the central core towards the periphery. The structure of dendrimers consists of a central core with layers of repeating units, followed by terminal functional groups [4]. The terminal functional groups are responsible for the pharmacokinetic properties of the structure. It provides the platform for the conjugation of different target-specific ligands for the effective delivery of drug molecules to target organs [5]. Therapeutic or diagnostic agents can be encapsulated inside the structure or can be tailored on the surface of the dendrimers. The structure of dendrimers increases radially, increasing the generation number from G0 to G5. Beyond G5, there is no increment in generation number due to the highly complex structure [6].
Dendrimers can alter the pharmacokinetics of the attached drug molecules by conjugating them with peptides, proteins, and specific antibodies. Dendrimers are nanosized structures and can easily penetrate through the skin, muscular layers, intestine, or epithelial layers. Dendrimers can be targeted to specific tissues, reducing drug toxicity and thus preventing the non-infected healthy cells and improving therapeutic levels [7]. Dendrimers are polyvalent and possess high solubility potential, which helps to improve the solubility of hydrophobic drugs [8, 9]. It also possesses the self-assembling property due to intermolecular forces which balance the individual forces. Due to self-assembling, supramolecular structure was generated, which possesses high drug-loading capacity [10].
Poly(propylene imine) (PPI) dendrimers are polar vesicles with spherical shapes. It consists of ethylene diamine (EDA) as a central core with branching of tertiary tris-propylene amine in the interior part of the dendrimers and primary alkylamine on the surface of the dendrimers [11, 12]. The structure possesses high branching of alkylamine PPI dendrimers in the internal part, rendering them hydrophobic in comparison to poly(amidoamine) (PAMAM) dendrimers. PPI dendrimers are available in a different generation from G0 to G5 [13].
Fosamprenavir calcium (FPV) is a prodrug. Once it is taken into the body, it is quickly converted to amprenavir by cellular phosphatases in the epithelium lining the stomach. There have been reports of skin responses that are either extremely severe or potentially fatal. Diarrhea, rash, nausea, vomiting, and headache are the most prevalent adverse effects that range from mild to severe in severity throughout clinical studies of Lexiva. Fosamprenavir calcium is available in film-coated tablets, capsules, and oral suspension [14].
The drug FPV is responsible for hemolytic anemia [15]; similarly, the dendrimers cause toxicity due to terminal amine groups [16]. Dendrimers are commonly administered through the intravenous route, and the formulations are first going to interact with blood cells. Hemolysis studies are the better indicator of the effect of formulations on the blood cell, especially red blood cells (RBCs). The test indicated the quantitative release of hemoglobin due to the lysis of cells. The study helps to determine the qualitative as well as quantitative damage to the RBCs by % hemolysis studies as well as by studying the cell morphology due to the presence of drug-loaded dendrimers [17].
The present work was designed to develop the formulation of the prodrug Fosamprenavir calcium-loaded 5G PPI dendrimer for the effective treatment of HIV. The dendrimers exhibit very high drug-loading capacity due to high internal spaces and surface functional groups. Thus, large amounts of drugs can be trapped inside or conjugated outside the dendrimers. The drug causes severe toxicity due to which they need to be administered in lower doses than required for effective plasma concentration. Lower drug administration leads to severe problems such as inefficient treatment, relapse of disease, and drug resistance. The developed formulation helps to accommodate a larger quantity of drug, thus helping in maintaining the effective blood concentration. Thus, the Fosamprenavir calcium-loaded dendrimers were formulated and characterization and in vitro drug release and hemolytic studies were performed.
The drug Fosamprenavir calcium (FPV) was procured from Lupin Laboratories Limited, Pune, India. 5G PPI dendrimers was received as a gift sample from Dr. N. K. Jain, Dr. H. S. Gour University, Sagar, India. The dialysis membrane of molecular weight cut-off (MWCO) 7 KDa was purchased from Himedia, India. All other chemical was of analytical grades.
Formulation development of FPV-loaded dendrimers
100 mg of drug FPV was weighed accurately. 20 ml of methanol was added to the drug and mixed well. The drug methanol solution was sonicated for 10 min to solubilize the drug completely. The above solution was transferred to a round bottom flask and then 10 ml water was added and to this accurately weighed 200 mg of carbon nanotubes was added. The preparation was stirred for 48 h using a magnetic stirrer. Following a period of 48 h, the solutions were dialyzed in a cellulose dialysis membrane bag (MWCO 7 KDa, Himedia, India) against water and methanol at a ratio of 2:1 while the sink condition was maintained. This process lasted for 15 min. The resultant product was collected and dried at 50±1 °C till it was completely dried. The dried product was collected and stored in an air-tight container for further characterization [18].
Characterization
Fourier transform infrared spectroscopy
Fourier transform infrared spectroscopy (FTIR) was performed to study the presence of functional groups in the pure drugs and it also helped to understand the conjugation of 5G PPI dendrimers with the drug Fosamprenavir calcium (FPV-DEN). The spectrum was determined using PerkinElmer Spectrum IR Version 10.6.1. The sample was pelleted with KBr pellets and placed under the beam of IR radiations. Different frequencies of light were indented on the samples and their corresponding absorption was noted. The functional group present in the sample responds to a specific frequency of light and corresponds to wave number. The samples of drug FPV, dendrimers, and FPV-DEN were subjected to FTIR spectroscopy for the confirmation of the functional groups [19].
Nuclear magnetic resonance spectroscopy
Nuclear magnetic resonance (NMR) spectroscopy is the confirmatory and most desirable analytical method to evaluate the chemical structure of raw materials. The samples of FPV, dendrimer, and FPV-DEN were subjected to NMR spectroscopy for structural confirmation. The samples were subjected to proton NMR (Bruker Advance II) at an operational frequency of 400 MHz. The samples were dissolved in dimethylsulfoxide (DMSO) [20].
Differential scanning calorimetry
Differential scanning calorimetry (DSC) study helped to evaluate the thermal properties of the drug FPV and the effect of thermal properties on the conjugation of a drug on dendrimers. The drugs FPV, 5G PPI dendrimers, and FPV-DEN were subjected to DSC studies. The sample was placed on the aluminum pan and packed properly. The heating rate was set from 2 °C/min using DSC (Perkin Elmer, Massachusetts, United States) [21].
Field emission scanning electron microscopy
5G PPI dendrimer and FVP-DEN structure's external surface properties, including porosity, fractures, and flaws, were studied using Field emission scanning electron microscope (FE-SEM). Studies on surface morphology were conducted using a 1.0 nm resolution FE-SEM (Jeol, USA, Inc.). A secondary detector was employed. A thin layer of gold was applied to the sample using a JFC ion sputter coater to prepare it. 15 kV of accelerated voltage was used for the scanning [22, 23].
Particle size
The particle size and zeta potential of the 5G PPI dendrimers were estimated by measuring the dispersion by Zetasizer Ver. 7.13, Malvern, using light scattering method [24].
Drug entrapment
It is an indirect approach that establishes the drug content in the solvent system, and the quantity of drug entrapped is determined by comparing the initial drug loading to the amount of drug in the solvent. The produced dispersion was shifted into a dialysis bag (MWCO 7 KDa, Himedia, India) following drug loading. The bag was placed in 40:60 methanol: water solution and stirred magnetically for 15 min. After 15 min, the solvent was removed, and a UV spectrophotometer (Shimadzu UV/Vis, Japan) was used to analyze the drug concentration at 265 nm for FPV [25]. % entrapment efficiency was determined using the formula given below:

In vitro drug release”
In vitro release study was performed by equilibrium dialysis tube diffusion technique. A dialysis bag (MWCO 7 KDa, Himedia, India) was used for the administration of 10 mg/5 ml of each drug-loaded dendrimers and 5G PPI dendrimers solution in methanol. Under sink circumstances, the constructed tube was dialyzed with methanol: buffer (PBS pH 7.4 and acetate buffer pH 5). 1 ml of the liquid sample was taken every hour until 8 h, then at 24 h, 30 h, 48 h, 72 h, and 96 h. To keep the sink condition, additional fresh solvent (1 ml) was applied. Using a UV spectrophotometer (Shimadzu UV/vis, Japan) at 265 nm for FPV the extracted sample was diluted using an appropriate solvent solution [26].
Release kinetics
Different mathematical models, including first order, zero order, Hixon-Crowell, the Korsmeyer-Peppas model, and the Higuchi model, were applied to the drug release data. To determine which model best matched the release profile, the R2 value was estimated. The first-order release shows a connection between drug dosage and response pace. The zero-order suggests that the conjugates continuously release their substance. The release of hydrophilic and sparingly soluble drugs by diffusion or dissolution is depicted in Higuchi's model. The Korsmeyer-Peppas model aids in correlating how the medicine diffuses across the polymeric matrix. Release methods and the n value (release exponent) may be connected. The n value may be used to study the diffusion pattern whether the value of n is less than 0.5 [27].
Hemolysis studies
A sample of blood was withdrawn from Wister rats in EDTA anticlot vials and centrifuged for 15 min at 3000 rpm using a Remi centrifuge. RBCs were first washed, and then 0.1 ml of RBC suspension was mixed with 0.9% saline solution and incubated for 60 min. After incubation, the sample was analyzed using a UV spectrometer (Shimadzu 1601, Kyoto, Japan) at 540 nm along with 0.9% w/v NaCl solution and deionized water to stimulate 0% and 100% hemolysis. Dilutions of the RBC suspension were made and analyzed by UV spectrophotometer. Hemolysis studies were carried out for the drug FPV, 5G PPI dendrimers, and formulation FPV-DEN was analyzed at increasing concentrations (0.3 µg/ml, 0.6 µg/ml, 0.9 µg/ml)[16, 28]. Percent hemolysis was calculated by the equation:

Where Abs, Abs0 and Abs100 are the absorbance of sample, a solution of 0% hemolysis and a solution of 100% hemolysis, respectively.
Formulation development of fosamprenavir calcium-loaded dendrimers
Fosamprenavir calcium-loaded dendrimers (FPV-DEN) was developed by loading drug FPV on the 5G PPI dendrimers with constant stirring for 48 h using a magnetic stirrer. The drug binds with the surface amine group of the dendrimers by covalent linkage and is also trapped in the dendrimer structure. The structure was characterized using different characterization techniques such as spectroscopic analysis, morphological studies, and cytotoxicity studies.
Characterization of FPV-DEN
FTIR spectroscopy
Fig. 1 shows the FTIR spectra of FPV, dendrimers, and FPV-DEN. FTIR spectrum of FPV indicated an intense peak at 3372.08 cm-1reflecting the presence of stretches of O-H; the medium intensity peak found at 3243.04 cm-1are the stretches of an amino group (N-H) corresponding to amide and amine functional group. A peak at 1688.01 cm-1was the peak of stretched of aliphatic C=O, the peak of higher intensity was observed at 1597.91 cm-1 and 1502.3 cm-1 confirms the stretches of C=C; medium intensity C=H stretches of the aliphatic isopropyl chain observed at 1431.79 cm-1, 1315.68 cm-1corresponds to stretching of C-N of the amine group, the peak showed high to medium intensity, 1147.81 cm-1 and 1089.53 cm-1 peaks correspond to an asymmetrical stretch of S=O; a region with high intensity, at 987.18 cm-1 the peak of high intensity due to C-O stretching of ether and phosphate esters [26, 29].
The spectrum of dendrimers showed peaks such as a peak at 3322.67 cm-1 was the peak for primary amine, confirming the presence of amine present on the periphery of dendrimers, a peak at 2832.0 cm-1, and a peak at 2944.47 cm-1 was due to-C-H stretching of alkene, peak at 1683.75 cm-1 indicates N-H deflection of amine, a peak at 1411.08 cm-1 and 1449.72 cm-1 are the twin peak corresponds to CH band, a peak at 1114.98 cm-1 due to stretching of–C-N, and 1029.07 cm-1which corresponds to bending C-H.
The drug conjugation took place between the methyl group of the isopropyl chain of drug FPV and the surface amino group of dendrimers. The spectrum of FPV-DEN showed a characteristic peak at 3353.66 cm-1, which corresponds to the broad peak of NH. The peak was found to be altered due to the incorporation of the drug in the dendrimer structure. The peak at 2958.05 cm-1 corresponds to the stretching of C-H and the peak at 1655.06 cm-1 corresponds to the carbonyl group (amide) of the drug FPV. The peak at 1596.04 cm-1 and 1503.00 cm-1 corresponds to C=C of the aromatic structure of drug FPV. The peak of the C-H group of the isopropyl group of FPV was sifted to at 1420.27 cm-1 and the peak shape was also altered, indicating that the drug structure had been altered due to conjugation of FPV with dendrimers. The C-N peak was observed at 1362.00 cm-1 and the characteristics peak of S=O was observed at 1079.46 cm-1confirming the presence of dendrimers. This confirms that the drug FPV was loaded on the surface of dendrimers [29]. Table 1 represents FTIR frequency data of plain drug FPV.

Fig. 1: FTIR spectrum of (a) FPV (b) Dendrimers (c) FPV-DEN

(a)

(b)

(c)
Fig. 2: NMR spectrum of (a) FPV (b) Dendrimers (c) FPV-DEN
Table 1: FTIR frequency data of FPV-DEN
| Observed peaks frequency (cm-1) | Standard FTIR range (cm-1) | Corresponding functional group |
| 3353.66 | 3500-3100 | Broad altered band of N-H stretching |
| 2958.05 | 3150-3050 | C-H stretching |
| 1655.06 | 1630-1680 | C=O (amide) group |
| 1596.04 | 1475-1600 | C=C aromatic carbon |
| 1503.00 | 1350-1000 | C=C aromatic carbon |
| 1420.27 | 1375-1450 | C-H isopropyl stretch |
| 1362.00 | 1300-1000 | -C-N stretch |
| 1079.46 | 1050-1375 | -S=O |
| 980.7 | 900-690 | -C-H aromatic (out of plane) |
NMR spectroscopy
The NMR spectrum of plain drug FPV, dendrimers, and FPV-DEN is shown in fig. 2. The drug was subjected to 1H NMR spectroscopy and studied for the presence of different peaks corresponding to different protons in the FPV structure, confirming the purity of the drug. H3 and H7 aromatic protons show their presence at H3 and H7 at δ 6.83 ppm, and other aromatic protons H4 and H6 show their doublet at δ 7.62 ppm. The H18, H19, and H20 show resonance at δ 7.21 to δ 7.23 ppm, a pair of doublets corresponding aromatic methine proton at H17 and H21 found at δ 7.30 ppm. Doublets observed at δ 0.77 and 0.78 ppm correspond to H10 and H11 of methyl proton. Five pairs of multiplets for methyl protons containing non-equivalent protons at δ 2.59-2.64 ppm, δ 2.97-2.99 ppm responded to H8a,b, δ 2.71-2.76 ppm, δ 3.53-3.54 ppm responded to H-12a,b, δ 2.55-2.59 ppm, δ 3.00-3.03 ppm responded to H-15a,b, δ 1.8 ppm, δ 1.93-1.95 ppm corresponded to H-25a,b, δ 3.2838-3.2889 ppm, δ 3.53-3.54 ppm corresponding to H-26a,b. Multiplets at δ 1.93 ppm, δ 3.7.3-8 ppm correspond to methine proton H9, H-13, H-14, and H-24. The H 27 a,b corresponds to δ 3.59-3.68 ppm, and doublets at δ 6.86 ppm correspond to the carbamate group [30].
The NMR spectrum of the 5G PPI dendrimer is shown in fig. 2b. The NMR spectra of dendrimers confirm the presence of protons as per the literature. Multiplets were observed between δ 0.9 ppm corresponding to-CH2 of methylene groups of EDA. The chemical shifts between δ 1.74 ppm corresponding to-CH2-CH2-, the peak at δ 2.34-2.36 ppm corresponds to-NH2, multiple peaks at δ 2.40–2.69 ppm due to N[C]C and multiplets between δ 2.71-2.79 ppm corresponds to-CH2-NH2 [31, 32].
The NMR spectra of FPV-DEN indicate many protons due to the incorporation of the drug FPV in the dendrimers, which were not present in the NMR spectra of dendrimers. Alteration in a chemical shift at δ 2.33 ppm indicated the attachment of the methyl group of the drug with a surface amino group of dendrimers. The multiplets at δ 0.7-0.8 ppm correspond to isopropyl methyl proton altered, indicating the attachment of the methyl group of the drug and terminal amine group of dendrimers. Aromatic protons are visible above δ 7.00 ppm, and chemical shift at δ 6.85 ppm corresponds to carbamate proton. The dendrimer structure has an abundance of protons in its surroundings due to a heavily conjugated and complex structure that corresponds to various peaks and splitting patterns [33].
Differential scanning calorimetry
The conjugation of FPV-DEN was also confirmed by DSC studies and given in fig. 3. DSC studies of dendrimer indicated that sharp peak at 88.6 °C. The peak was observed at 315.53 °C for FPV and 104.3 °C for the drug-loaded dendrimers. It was observed that the transition temperature showed a negative shift, confirming the strong interactions between dendrimers and FPV. The transition of the peak indicated that the endothermic capability was altered, which confirmed that the drug was conjugated with dendrimers [34].

Fig. 3: DSC images of (a) FPV (b) Dendrimers (c) FPV-DEN
Field emission scanning electron microscopy”
Fig. 4 represents the image of dendrimers and FPV-DEN. The FE-SEM image indicated that the surface topography did not change when the drug was loaded in the dendrimer structure. The image indicated that the structure of dendrimers in drug-loaded dendrimers remained unchanged as compared to plain dendrimers. Spherical structure dendrimers were observed in the microscopic image indicating that the process of drug loading did not alter the surface topography of the dendrimer. The structural characteristics did not alter the conjugation of the drug [35].
Particle size distribution
The particle size of dendrimers and FPV-DEN were determined using Delsa nano (Beckman counter). Fig. 5 shows the particle size distribution of FPV-DEN. The particle size of the dendrimers was found to be 41.9±1.02 nm and PDI was found to be 0.379. The particle size of drug-loaded dendrimers was found to be 172.6±0.89 nm and PDI was found to be 0.379. The result indicated that the prepared drug-loaded dendrimer was found to be in the nano-range and PDI indicated that the structure is uniformly distributed. Table 2 represents the particle size and PDI of dendrimers and FPV-DEN.

Fig. 4: FE-SEM images, (a) Dendrimer (at 15,000x magnification); (b) FPV-DEN (at 25,000x magnification)

Fig. 5: Particle size distribution of FPV-DEN
Table 2: Particle size and zeta potential of dendrimer and FPV-DEN
| Particle size (nm) | PDI | |
| 5G PPI Dendrimer | 41.9±1.02 | 0.379 |
| FPV-DEN | 172.6±0.89 | 0.379 |
*(Data is represented as mean±SD, n=3)
Entrapment efficiency
Entrapment efficiency was performed using a dialysis membrane to determine the amount of entrapped drug in the carrier system. The drug entrapment efficiency FPV-DEN was determined using an indirect method using a dialysis membrane (MWCO 7 KDa, Himedia, India). The entrapment efficiency was found to be 69.83±0.31%. The terminal functional group increases the sites of interaction of drugs by covalent linking and also binds non-covalently by hydrogen bonding or hydrophobic interactions as the drug was also hydrophobic. The drug can also entrap and form bonds inside the dendritic structure [36].
In vitro drug release
The drug release studies of FPV-DEN were performed in two different pH media, i.e., at PBS pH 7.4 which corresponds to systemic pH, and at acetate buffer pH 5, which corresponds to the internal environment of the macrophages. The study involves 50 ml of release medium kept on continuous stirring. The dialysis membrane method used for the release study revealed initial fast release followed by sustained release in both the release medium. The drug FPV was reported to have higher solubility at lower pH (pH 3.3), which reduces with increases in pH [37]. The release study revealed the higher drug release at lower pH 5 (88.79±1.10%) as compared to pH 7.4 (78.59±2.41%). Fig. 6 shows the drug release profile of FPV from FPV-DEN in acetate buffer pH 5 and PBS pH 7.4 for 96 h.
Drug release kinetics
Different mathematical models are used to correlate the release pattern zero and first order, Higuchi model, Korsmeyer-Peppas model, and Hixon-Crowell model. The results were tabulated in table 3 and represented in fig. 7. The most-fitted model was based on the value of regression; the higher the value, the better the model fitted.

Fig. 6: Drug release profile of FPV-DEN for 96 h, *(Data is represented as mean±SD, n=3)
Table 3: Drug release kinetics showing R2 value and n
| S. No. | Release | pH 5 | pH 7.4 | ||
| R2 | n | R2 | N | ||
| 1 | First-order | 0.85 | 0.8404 | ||
| 2 | Zero-order | 0.68 | 0.716 | ||
| 3 | Korsmeyer-Peppas | 0.7235 | 0.6667 | 0.6816 | 0.5974 |
| 4 | Higuchi | 0.9052 | 0.909 | ||
| 5 | Hixon | 0.7961 | 0.8015 | ||
Both the release profiles were subjected to the release kinetics model and the R2 value was calculated. From the kinetics model, it was concluded that the most-fitted model was found to be the Higuchi model with the highest R2 value of 0.9052 for pH 5 and 0.909 for pH 7.4. The release exponent indicated the drug transport mechanism through the polymer. The Higuchi model helps to understand the drug release from an insoluble matrix. The release pattern showed an initial fast release followed by a decrease in release with time. In this system concentration of the drug is much higher than it releases and acts as a driving force. As time proceeds, the concentration gradient changes reducing the diffusion and subsequently reducing the drug release [38]. The parameter n helps to determine the release mechanism of the drug from the delivery system. If the value is less than o.5 then fickian diffusion was supposed to follow, if the value is between 0.5 to 1 non-fickian mechanism was followed. If the value of n is 1, the release is by swelling and diffusion comes under non-fickian diffusion (Case II), and then if the value of n>1, it is a super case II model. The n value was found to be 0.6667 for pH 5 and 0.5974 for pH 7.4. The value indicates that the release was governed by the fickian diffusion model.
The drug release was subjected to other release models; the lowest R2 value was found to be for the first order. The value for the first order was found to be 0.85 for pH 5 and 0.8404 for pH 7.4, a lower value of R2 makes it unsuitable. The zero-order model was also unsuitable as the value of the correlation coefficient was 0.68 for pH 5 and 0.716 for pH 7.4. The Higuchi model also showed a lesser R2 value of around 0.7235 for pH 5 and 0.6816 for pH 7.4. The Hixon Crowell model was also found unsuitable as the value of R2 was found to be 0.7961 for pH 5 and 0.8015 for pH 7.4.


(a) First order release kinetics (b) Zero order release kinetics


(c) Korsmeyer peppas release kinetics (d) Higuchi release kinetics

(e) Hixon-Crowell release kinetics
Fig. 7: Drug release kinetics of FPV-DEN
Hemolysis study
Hemolysis study helps to study the effect of the formulation on cell lysis, particularly RBC lysis. PPI dendrimers cause hemolysis due to terminal amine groups of dendrimers. The drug FPV also induces hemolytic anemia as reported by the Food and Drug Administration (FDA) [15]. The plain drug showed very high hemolytic activity (47.07±1.28%). The hemolytic tendency of the drug and dendrimer drastically changed on conjugation. Upon conjugation free drug was not available that reduces the toxicity and thus, RBCs lysis similarly the terminal amine group of dendrimers was occupied by the drug reducing its toxicity. Fig. 8 represents the % hemolysis data of the drug FPV, 5G PPI dendrimers, and three different concentrations of FPV-DEN.
The percentage hemolysis of the formulation was tested at three different levels, demonstrating that toxicity increased with the dose of the formulation [39-41]. The toxicity of the formulation increases as the formulation's concentration rises. At the formulation concentrations of 0.3, 0.6, and 0.9 µg/ml, the toxicity was found to be 5.45±0.99%, 12.12±1.25%, and 22.82±1.08% [22, 23]. RBCs were photographed after being exposed to various formulation concentrations, FPV, as well as saline and water. When RBCs were treated with 0.9% saline, the images revealed no lysis; however, full lysis was shown when RBCs were treated with water. The formulation at a lower concentration (0.3% µg/ml) does not show hemolysis, while hemolysis increases with increasing concentration. Fig. 9 represents the photograph of RBCs treated with saline, water, drug FPV, 5G PPI dendrimers, and FPV-DEN at 0.3%, 0.6%, and 0.9% µg/ml concentration.

Fig. 8: % Hemolysis by FPV, 5G PPI dendrimers, and different concentration of formulations, *(Data is represented as mean±SD, n=3)

(a) Saline (b) Water


(c) FPV (d) 5G PPI Dendrimers


(e) FPV-DEN (0.3 µg/ml) (f) FPV-DEN (0.6 µg/ml)

(g) FPV-DEN (0.9 µg/ml)
Fig. 9: Surface morphology of RBCs-(a) Saline, (b) Water, (c) Drug FPV, (d) 5G PPI dendrimers, (e) FPV-DEN (0.3 µg/ml), (f) FPV-DEN (0.6 µg/ml), and (g) FPV-DEN (0.9 µg/ml)
Dendrimers are a novel cargo system for the delivery of the drug. Dendrimers have high drug loading capacity within the dendrimer structure and on the surface amino group of dendrimers. In the present work, the drug Fosamprenavir calcium was loaded on the 5G PPI dendrimers. The drug gets trapped inside and conjugated on the surface amino group of dendrimers. The conjugation was confirmed by spectroscopic techniques and DSC. The drug release studies and release kinetics revealed the effective release for 96 h. The hemolytic study indicated that the RBC lysis due to drug FPV and dendrimers was found to be reduced drastically after conjugation. From the present study, it can be concluded that a drug FPV can be effectively loaded on dendrimers for the treatment of disease.
Nil
The authors thank Lovely Professional University for providing the facilities to conduct the experimental work.
Declared none
Sherje AP, Jadhav M, Dravyakar BR, Kadam D. Dendrimers: a versatile nanocarrier for drug delivery and targeting. Int J Pharm. 2018;548(1):707-20. doi: 10.1016/j.ijpharm.2018.07.030, PMID 30012508.
Abbasi E, Aval SF, Akbarzadeh A, Milani M, Nasrabadi HT, Joo SW. Dendrimers: synthesis, applications, and properties. Nanoscale Res Lett. 2014;9(1):247. doi: 10.1186/1556-276X-9-247, PMID 24994950.
Mishra V, Kesharwani P, Amin MC, Iyer A. Nanotechnology-based approaches for targeting and delivery of drugs and genes. Academic Press; 2017.
Nath J. Dendrimers: a review on its snythesis, types, properties and applications. Int J Curr Pharm Sci. 2022;14(2):21-5. doi: 10.22159/ijcpr.2022v14i2.1964.
Mishra V, Jain NK. Acetazolamide encapsulated dendritic nano-architectures for effective glaucoma management in rabbits. Int J Pharm. 2014;461(1-2):380-90. doi: 10.1016/j.ijpharm.2013.11.043, PMID 24291772.
Mishra V, Gupta U, Jain NK. Surface-engineered dendrimers: a solution for toxicity issues. J Biomater Sci Polym Ed. 2009;20(2):141-66. doi: 10.1163/156856208X386246, PMID 19154667.
Yellepeddi VK, Ghandehari H. Pharmacokinetics of oral therapeutics delivered by dendrimer-based carriers. Expert Opin Drug Deliv. 2019;16(10):1051-61. doi: 10.1080/17425247.2019.1656607, PMID 31414922.
Choudhary S, Gupta L, Rani S, Dave K, Gupta U. Impact of dendrimers on solubility of hydrophobic drug molecules. Front Pharmacol. 2017;8:261. doi: 10.3389/fphar.2017.00261, PMID 28559844.
Santos A, Veiga F, Figueiras A. Dendrimers as pharmaceutical excipients: synthesis, properties, toxicity and biomedical applications. Materials (Basel). 2019;13(1):65. doi: 10.3390/ma13010065, PMID 31877717.
Murugan E, Geetha Rani DP, Srinivasan K, Muthumary J. New surface hydroxylated and internally quaternised poly(propylene imine) dendrimers as efficient biocompatible drug carriers of norfloxacin. Expert Opin Drug Deliv. 2013;10(10):1319-34. doi: 10.1517/17425247.2013.801957, PMID 23789895.
Kesharwani P, Gothwal A, Iyer AK, Jain K, Chourasia MK, Gupta U. Dendrimer nanohybrid carrier systems: an expanding horizon for targeted drug and gene delivery. Drug Discov Today. 2018;23(2):300-14. doi: 10.1016/j.drudis.2017.06.009, PMID 28697371.
Mishra V, Kesharwani P. Dendrimer technologies for brain tumor. Drug Discov Today. 2016;21(5):766-78. doi: 10.1016/j.drudis.2016.02.006, PMID 26891979.
Kaur A, Jain K, Mehra NK, Jain NK. Development and characterization of surface-engineered PPI dendrimers for targeted drug delivery. Artif Cells Nanomed Biotechnol. 2017;45(3):414-25. doi: 10.3109/21691401.2016.1160912, PMID 27027686.
Crowe SM, Katlama C, Murphy R. Fosamprenavir. In: Kucers. The use of antibiotics. CRC Press; 2017. p. 4104-20.
https://www.accessdata.fda.gov/drugsatfda_docs/label/2013/021548s031,022116s015lbl.pdf [Last accessed on 20 May 2023]
Aljabali AA, Obeid MA, Bashatwah RM, Serrano Aroca A, Mishra V, Mishra Y. Nanomaterials and their impact on the immune system. Int J Mol Sci. 2023;24(3):2008. doi: 10.3390/ijms24032008, PMID 36768330.
Mishra V, Gupta U, Jain NK. Influence of different generations of poly(propylene imine) dendrimers on human erythrocytes. Pharmazie. 2010;65(12):891-5. doi: 10.1691/ph.2010.9385, PMID 21284258.
Singh V, Sahebkar A, Kesharwani P. Poly (propylene imine) dendrimer as an emerging polymeric nanocarrier for anticancer drug and gene delivery. Eur Polym J. 2021;158. doi: 10.1016/j.eurpolymj.2021.110683.
Kesharwani P, Mishra V, Jain NK. Generation dependent hemolytic profile of folate engineered poly (propyleneimine) dendrimer. J Drug Deliv Sci Technol. 2015;28:1-6. doi: 10.1016/j.jddst.2015.04.006.
Zhang M, Guo R, Keri M, Banyai I, Zheng Y, Cao M. Impact of dendrimer surface functional groups on the release of doxorubicin from dendrimer carriers. J Phys Chem B. 2014;118(6):1696-706. doi: 10.1021/jp411669k, PMID 24467521.
Chountoulesi M, Naziris N, Pippa N, Pispas S, Demetzos C. Differential scanning calorimetry (DSC): an invaluable tool for the thermal evaluation of advanced chimeric liposomal drug delivery nanosystems. In: Demetzos C, Pippa N, editors. Thermodynamics and biophysics of biomedical nanosystems. Springer, Singapore; 2019. p. 297-337. doi: 10.1007/978-981-13-0989-2_9.
Shi F, Zhuang X, Cui C, Zhang S. Synthesis, characterization and scale inhibition performance evaluation of novel dendrimers with the initiator core of pentaerythritol derivative. Desalination. 2022;528:115632. doi: 10.1016/j.desal.2022.115632.
Kohli S, Pal A, Jain S. Preparation, characterization and evaluation of poly (Lactide–co–glycolide) microspheres for the controlled release of zidovudine. Int J Pharm Pharm Sci. 2017;9(12):70-7. doi: 10.22159/ijpps.2017v9i12.18377.
Youssry M, Al-Ruwaidhi M, Zakeri M, Zakeri M. Physical functionalization of multi-walled carbon nanotubes for enhanced dispersibility in aqueous medium. Emergent Mater. 2020;3(1):25-32. doi: 10.1007/s42247-020-00076-3.
Parashar AK, Gupta AK, Jain NK. Synthesis and characterization of Agiopep-2 anchored pegylated poly propyleneimine dendrimers for targeted drug delivery to glioblastoma multiforme. J Drug Deliv Ther. 2018;8(6-A):74-9.
Jain NK, Tare MS, Mishra V, Tripathi PK. The development, characterization and in vivo anti-ovarian cancer activity of poly(propylene imine) (PPI)-antibody conjugates containing encapsulated paclitaxel. Nanomedicine. 2015;11(1):207-18. doi: 10.1016/j.nano.2014.09.006, PMID 25262579.
Golshan M, Salami Kalajahi M, Roghani Mamaqani H, Mohammadi M. Synthesis of poly(propylene imine) dendrimers via homogeneous reduction process using lithium aluminium hydride: bioconjugation with folic acid and doxorubicin release kinetics. Applied Organom Chemis. 2017;31(11):e3789. doi: 10.1002/aoc.3789.
Janaszewska A, Lazniewska J, Trzepinski P, Marcinkowska M, Klajnert Maculewicz B. Cytotoxicity of dendrimers. Biomolecules. 2019;9(8):330. doi: 10.3390/biom9080330, PMID 31374911.
Cordeiro CF, Bettio I, Trevisan MG. Studies on the characterization and polymorphic stability of fosamprenavir. An Acad Bras Cienc. 2020;92(1):e20181021. doi: 10.1590/0001-3765202020181021, PMID 32401841.
Singh DK, Sahu A, Wani AA, Bharatam PV, Kotimoole CN, Batkulwar KB. Stability behaviour of antiretroviral drugs and their combinations. 10: LC-HRMS, LC-MSn, LC-NMR and NMR characterization of fosamprenavir degradation products and in silico determination of their ADMET properties. Eur J Pharm Biopharm. 2019;142:165-78. doi: 10.1016/j.ejpb.2019.06.018, PMID 31226366.
Kumar PV, Asthana A, Dutta T, Jain NK. Intracellular macrophage uptake of rifampicin-loaded mannosylated dendrimers. J Drug Target. 2006;14(8):546-56. doi: 10.1080/10611860600825159, PMID 17050121.
Gajbhiye V, Ganesh N, Barve J, Jain NK. Synthesis, characterization and targeting potential of zidovudine loaded sialic acid conjugated-mannosylated poly(propyleneimine) dendrimers. Eur J Pharm Sci. 2013;48(4-5):668-79. doi: 10.1016/j.ejps.2012.12.027, PMID 23298577.
Monteiro MSSB, Chavez FV, Sebastiao PJ, Tavares MIB. 1H NMR relaxometry and X-ray study of PCL/nevirapine hybrids. Polym Test. 2013;32(3):553-66. doi: 10.1016/j.polymertesting.2013.01.016.
Ramana LN, Sethuraman S, Ranga U, Krishnan UM. Development of a liposomal nanodelivery system for nevirapine. J Biomed Sci. 2010;17(1):57. doi: 10.1186/1423-0127-17-57, PMID 20624325.
Yang S, Liu J, Ping Y, Wang Z, Zhang J, Zhang L. Multi-functionalized single-walled carbon nanotubes as delivery carriers: promote the targeting uptake and antitumor efficacy of doxorubicin. J Incl Phenom Macrocycl Chem. 2022;102(9-10):801-17. doi: 10.1007/s10847-022-01163-0.
Tripathi PK, Gupta S, Rai S, Shrivatava A, Tripathi S, Singh S. Curcumin loaded poly (amidoamine) dendrimer-plamitic acid core-shell nanoparticles as anti-stress therapeutics. Drug Dev Ind Pharm. 2020;46(3):412-26. doi: 10.1080/03639045.2020.1724132, PMID 32011185.
Ford SL, Wire MB, Lou Y, Baker KL, Stein DS. Effect of antacids and ranitidine on the single-dose pharmacokinetics of fosamprenavir. Antimicrob Agents Chemother. 2005;49(1):467-9. doi: 10.1128/AAC.49.1.467-469.2005, PMID 15616339.
Rompicherla NC, Joshi P, Shetty A, Sudhakar K, Amin HIM, Mishra Y. Design, formulation, and evaluation of aloe vera gel-based capsaicin transemulgel for osteoarthritis. Pharmaceutics. 2022;14(9):1812. doi: 10.3390/pharmaceutics14091812, PMID 36145560.
Srivastava N, Mishra Y, Mishra V, Ranjan A, Tambuwala MM. Carbon nanotubes in breast cancer treatment: an insight into properties, functionalization, and toxicity. Anticancer Agents Med Chem. 2023;23(14):1606-17. doi: 10.2174/1871520623666230510094850, PMID 37165493.
Srivastava N, Mishra Y, Mishra V. Importance of nanocarriers in colon cancer. In: Mishra N, Garg A, Upmanyu N, editors. Therapeutic nanocarriers in cancer treatment: challenges and future perspective. Singapore: Bentham Science Publishers; 2023. p. 228-54.
Sharma S, Mishra Y, Bisht S, Sharma N, Mishra V. An overview of biomaterial toxicity and excretion. In: Aljabali AA, Pal K. editors. Bionanotechnology: next-generation therapeutic tool. Singapore: Bentham Science Publishers; 2022. p. 1-29.